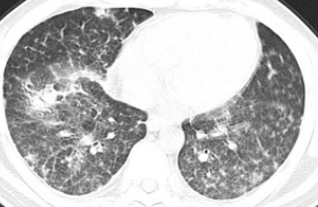

2018年11月8日上午,广州医科大学附属第一医院国家呼吸系统疾病疾病临床医学研究中心(以下简称“临床研究中心”)组织召开全国呼吸疾病临床-病理联盟病理视频网络讨论会。参加视频讨论的单位及专家有:临床研究中心主任钟南山院士、呼吸病理中心顾莹莹教授、广医一院呼吸内科罗群教授、孙宝清教授;北京协和医院冯瑞娥教授;同济大学附属同济医院易祥华教授;南京鼓楼医院孟凡青教授;福建医科大学附属第一医院张声教授,以及全国呼吸病理联盟的其他成员实时线上参与讨论,直播观看点击达499人次。会议由呼吸病理中心顾莹莹教授主持。


【院士致辞】
临床研究中心主任钟南山院士对线上线下参与讨论单位的专家学者表示热烈的欢迎。他指出,临床-病理联盟病例视频网络讨论会是一个很好的开始,我们应该发挥临床-病理协作联盟的力量,在病理领域进行大数据的积累,结合病理专家的分析,进行人工智能的开发,形成大数据加人工智能的模式。希望通过临床中心的平台将大数据库做起来,希望临床-病理协作联盟在我国的病理领域做出更大的贡献。

【呼吸病理中心顾莹莹教授主持】
【出片单位】
本次疑难病例共3例,出片单位分别为:北京协和医院、上海同济大学附属医院、临床研究中心呼吸疾病临床-病理联盟。
病例一:由临床研究中心呼吸疾病临床-病理联盟提供
侯XX,女,35岁, 病理号:A*****
主诉:反复胸闷,胸痛二月余;
病史:患者于二月余前因劳累及闻及刺激性气味出现胸闷,胸痛,偶尔有咳嗽,伴有关节疼痛及指端遇冷后麻木,疼痛,无咳痰,无喘鸣,在当地三甲医院就诊,血嗜酸性粒细胞显著升高:最高达28%,诊断为支气管哮喘、过敏性鼻炎,给予激素及抗过敏治疗,未规律服药治疗,症状可由药物控制及自行缓解。目前患者胸闷,胸痛症状仍反复发作而来我院就诊。
入院诊断:嗜酸性粒细胞性肺炎??
影像学检查

两肺可见散在小结节状、斑片状密度增高影及模糊影、少许条索影
影像学诊断:
1、两肺散在病灶,考虑炎症,嗜酸性粒细胞性肺炎?
2、双侧筛窦、左侧额窦及右侧上颌窦炎症。
入院后检查:
查体:雷诺现象,关节疼痛。可疑性Gottron’s疹
血常规:嗜酸性粒细胞比率:30.1%、嗜酸性粒细胞数:1.60 10^9/L
辅助检查:总IgE(TIgE):4567、抗核抗体定量:190.01U/mL、抗SS-A抗体:强阳性(+++)、D二聚体(ELISA法):1106ng/ml
肌电图示:所测神经-肌肉未见异常
无痛胃镜示:慢性非萎缩性胃炎伴糜烂
病理切片:

病例二:由北京协和医院提供
患者,男,33岁,病理号:1*****
主诉:“间断发热1年”
现病史:患者2017年3月受凉出现发热,最高温 39℃,外院考虑“大叶性肺炎”,抗感染治疗40天后退热。2余月后再次发热,最高温 38℃,外院CT:双肺散在淡片及结节影,予以甲强龙治疗3天,热退,停药再次发热。2017年6月来我院就诊,我院血常规:WBC 4.51×109/L,Neut% 73.5%,HGB 87g/L,PLT 89×109/L。ESR 83mm/h,hsCRP 176.26 mg/L。血培养、痰培养、CMV、EBV、G试验、GM试验、T.SPOT.TB均阴性。ANA18项、ANCA3项均阴性。HRCT:双肺弥漫密集分布微结节。PET/CT:右锁骨上代谢异常淋巴结,SUVmax 5.6,双肺弥漫分布大量微结节,多分布于支气管血管束及小叶间隔,摄取轻度增高,SUV1.5-4.3。支气管镜:镜下正常。BALF病原均阴性。TBLB(右下肺):肺泡间质增宽,纤维组织增生,肺泡上皮增生,肺泡见脱落细胞及吞噬细胞。TBLB (左下肺):少许支气管黏膜及肺组织显慢性炎,II型上皮细胞增生,肺泡间隔略增宽,肺泡腔内可见吞噬色素的吞噬细胞聚集,未见明显的纤维化,特染证实部分的吞噬细胞内可见含铁血黄素沉积。特染结果:普鲁士蓝(+)。考虑结核不除外,经四联诊断性抗结核+泼尼松10mg治疗,2017年10月复查HRCT:双肺弥漫性粟粒样结节影,部分新发,其余同前。停用抗结核药和激素,3天后再次发热,最高温39℃,自服中药后降温。2017年12月再次发热。胸增强CT:右下肺肺炎;双肺弥漫性粟粒样结节较前增大。于朝阳医院职业病门诊考虑电焊工尘肺,因该病有自然缓解倾向,予观察。因反复发热,2018年3月朝阳医院就诊,HRCT显示双肺弥漫性异常改变,考虑肺癌或肺内转移瘤伴广泛癌性淋巴管炎可能。朝阳医院职业病科考虑病程进展快,与电焊工尘肺不符。患者2018年4行“VATS右肺上叶楔形、右肺中叶楔形活检术”
既往史:2017年6月发现贫血、血小板低。2017年12月,RET% 5.82%,血涂片:红细胞大小不等,中心淡染区扩大,血小板数量减少; 骨髓涂片:增生活跃,粒红比=1.43:1,原粒0.5-1%,部分粒细胞胞浆颗粒减少或缺如,可见个别双核粒细胞及巨变,中性分叶核粒细胞可见多叶及巨变。红系各阶段比例增高,核畸形易见,红细胞大小不等,部分红细胞中心淡染区扩大。白血病基因41项(MDS系列): ASXL1突变。染色体:46XY,+1,der(1;12)(q10;q10)[10]。予益比奥、达那唑、叶酸治疗。
个人史:2005-2008年从事无防护电焊工作,有粉尘接触史;2017-2月接触煤灰半月;2009年至今从事钢窗安装工作;吸烟10余年,20支/日,饮酒10年,戒烟、戒酒1年。
婚育史:女儿自幼(3岁)患肺含铁血黄素沉积症
家族史:父亲患慢性阻塞性肺病、肺心病。
辅助检查:血常规:WBC 4.25×109/L, HGB 63-71g/L,PLT 25-65×109/L。尿、便常规正常。肝肾功: LD 326U/L↑,余正常。凝血正常。ESR 4mm/h,hsCRP 21.14mg/L。CMV、EBV-DNA、PCT、血培养、痰培养、 G试验、GM试验、IgE、mx2、m3、TB-SPOT均阴性。Cyfra211 17.36ng/ml↑,NSE 25.5ng/ml↑,CEA、AFP、CA19-9、CA242、SCCAg均正常。PET/CT:与2017-7-3日比较:1.原双肺代谢增高粟粒样结节大致同前,新出现多发大小不等结节及斑片影,代谢增高,SUVmax 2.9,双肺门及纵隔、右侧锁骨上/下、腋下、腹股沟多发代谢增高淋巴结,较前增多、增大,SUVmax 1.5-3.5。肺功能:限制性通气功能障碍,弥散功能减低,舒张试验阴性(FEV1/FVC 84.23%,FEV1 L/%,TLC 6.34/63.1%,DLCO 3.3/31.6%)。支气管镜检查:镜下大致正常。BALF:病原及液基细学均阴性,送检病原二代测序有少量上呼吸道细菌。
入院查体: T:36.6℃ P:100次/分 R:20次/分 BP:110/60mmHg SpO2:98%。双侧颌下可触及0.5*0.5cm淋巴结,质韧、活动可、无压痛。双肺呼吸音粗,未闻及干湿性啰音,心肺查体阴性,双下肢不肿。
入院诊断:发热、双肺多发结节原因待查;骨髓增生异常综合征。
影像学资料:

2017年3月

2017年7月
2018年2月

2018年3月
病理大体所见:
A(右上肺病变组织)楔形切除部分肺组织,大小5.4x1.8x1.2cm,附缝钉长6cm,表面部分被包膜,沿大面切开,切面见一实变区 ,大小2x1.8x1.5cm。
B(右肺中叶病变组织)楔形切除部分肺组织,大小3.6x1.5x0.8cm,附缝钉长3.8cm,表面大部被包膜,肺膜表面可见囊泡两枚,直径均为0.2cm,沿大面切开,切面可见一实变区,大小3.3x1.7x1cm。
病理切片:

病例三:由同济大学附属同济医院提供
刘XX,男,63岁, 病理号:H*****
主诉:左上肺占位十余天
病史:患者十天前因行“腹股沟疝修补术”至胃肠病区就诊,术前查胸部CT示“两肺多发大小不等结节灶,较大者位于左肺上叶”,无咳嗽、咳痰、胸闷、气促,无发热、盗汗、乏力等相关症状,现患者术后恢复良好,为求进一步诊治入我科,门诊拟“肺肿物”收治入院。患者自发病来,神清,精神可,胃钠夜睡眠可,二便无特殊,体重无明显改变。患者有高血压病史,现服用康忻,自述血压波动较大,有心脏病史,2011年行支架植入术,否认糖尿病病史;否认肝炎、结核等传染病病史。
2017年10月5日胸部CT示左肺上叶结节影,边界光整,大小约11*12mm,两肺多发大小不等结节灶。
入院诊断:肺部占位?
影像学检查



左肺上叶结节影,边界光整,大小约11*12mm,两肺见多发大小不等结节灶。
手术所见:胸腔镜下行肺叶部分(左肺上叶结节)切除术,术中探查见肿块约2*1.5*1cm大小,位于前段与舌段交界处。
化验室检查未见特殊。
病理切片:

各单位的专家就这三个病例分别进行了热烈的讨论和精彩点评。
【病理专家也说大数据】

冯瑞娥教授认为:大数据是趋势,病理上更注重诊断方面,特别是复杂的病例的诊断,看的是具体问题。少见病的数量虽少,但可以通过联盟联合起来,逐渐积累,形成病理的大数据,做出一些有意义的工作。

易祥华教授表示:我们应该结合国家丰富的病理资源做一些切实的工作,联盟首先要解决诊断问题,把平台打通,把疑难病例拿出来交流。再者,要有计划的分工协作,先从几个疾病开始逐渐积累,把临床资料、病理资料,影像资料等数据完整地积累,总结出来中国人的疾病谱。

孟凡青教授指出:首先要临床和病理真正做到融合。病理医生常常注重肿瘤的诊断,由于临床知识缺乏,活检标本比较少,对于非肿瘤的诊断不太擅长。临床-病理协作联盟可邀请更多的临床医生参与讨论,做到临床和病理的真正融合。再者要扩大临床-病理协作联盟影响力。很多非肿瘤病变可能在基层医院被忽略,我们应该利用多种形式宣传联盟,通过方便的收集方式,在全国范围内收集基层病例,及时反馈,以此筛选好的病例,积累数据。

张声教授提及:大数据是一个方向,可以从小数据做起,先从几个疾病的做起,做出成果,吸引更多人参与进来。联盟应当吸引更多的临床医生加入,探讨一些疑难但没做活检或手术的病例,在初诊时做活检通过形态学或基因检测,对每一种非肿瘤性的疾病做出更高层次的认识。
临床研究中心主任钟南山院士总结指出:病理在临床诊断中起关键作用。第一:加强临床和病理的联系很重要。今天我们通过联盟的平台,做出了初步的尝试。第二:要注重联盟平台的宣传,让更多人关注病理,扩大病理的影响,发挥病理在最后诊断中关键作用。第三:要注重非肿瘤性病例的病理数据积累。中国的病理做的肿瘤性的诊断做的比较多,实际上非肿瘤性病理中也有很多学问,对非肿瘤的病理研究还要大大加强,积累少见病、罕见病的数据。
点击下方链接,回看精彩视频!
视频链接
http://live.vhall.com/646292902?shareId=u-22241157-3
附:
国家呼吸系统疾病临床医学研究中心临床-病理协作联盟成员名单
会 长:钟南山 院士(广州医科大学附属第一医院)
副会长:陈荣昌 教授(广州医科大学附属第一医院)
顾莹莹 教授(广州医科大学附属第一医院)
冯瑞娥 教授(北京协和医院)
易祥华 教授(同济大学附属同济医院)
常 委:蔡国平 教授(耶鲁大学)
孟凡青 教授(南京大学医学院附属鼓楼医院)
蒋莉莉 教授(四川大学华西医院)
张 声 教授(福建医科大学第一附属医院)
委 员:成志强 教授(深圳市人民医院)
李晟磊 教授(郑州大学第一附属医院)
高 杰 教授(解放军总医院)
高金莉 教授(同济大学附属东方医院)
韩昱晨 教授(上海交通大学附属胸科医院)
蒋 谊 教授(中南大学湘雅二院)
刘加夫 教授(福建省福州肺科医院)
刘驯骅 教授(广东省人民医院)
芮炜玮 教授(上海交通大学附属瑞金医院)
武春燕 教授(同济大学附属上海市肺科医院)
曲利娟 教授(解放军福州总医院)
张晓云 教授(上海中医药大学附属龙华医院)
欧阳能太 教授(中山大学孙逸仙纪念医院)
秘 书:刘春平 博士(广州医科大学附属第一医院)
文稿:梁文燕、张冬莹
审稿:顾莹莹
编辑:关嘉铭